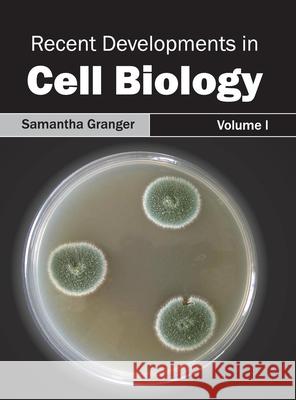
Recent Developments in Cell Biology: Volume I Samantha Granger 9781632395306 Callisto Reference - książka

Recent Developments in Cell Biology: Volume I » książka
topmenu
Recent Developments in Cell Biology: Volume I
ISBN-13: 9781632395306 / Angielski / Twarda / 2015 / 220 str.
This book attempts to understand the multiple branches that fall under the definition of cell biology and how such research has practical applications in our lives. The various concepts that are constantly contributing towards advancing technologies and the evolution of this field are looked at in detail here. Those in search of information to further their knowledge of this field will be greatly assisted by this book.